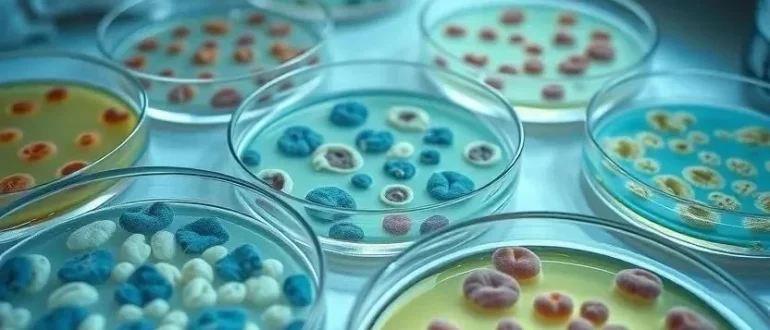

Болезни растений
Узнайте о передовых молекулярно-генетических методах диагностики бактериальных инфекций! Точное определение причины – залог эффективного лечения и спасения жизней.
Узнайте, как распознать бактериальную инфекцию, когда нужны антибиотики и как защититься! Разбираемся в отличиях от вирусов и эффективном лечении.
Листья в пятнах, стебли гниют? Узнайте, как распознать и вылечить бактериоз комнатных растений! Советы по профилактике и спасению ваших зеленых питомцев.
Антибиотикорезистентность – серьезная угроза здоровью планеты! Узнайте, как международное сотрудничество помогает бороться с бактериями и спасает жизни. Подробности здесь!
Узнайте, как современные методы лабораторной диагностики помогают выявить бактериальные инфекции! От микроскопии до ПЦР – всё о точном определении бактерий и эффективном лечении.
Резко ухудшилось состояние? Узнайте о сепсисе (заражении крови) – опасной реакции организма на инфекцию. Симптомы, первая помощь и почему важно действовать быстро!
Узнайте о последних достижениях в борьбе с бактериальными инфекциями! Конференции и семинары для специалистов: диагностика, лечение, профилактика. Остановим устойчивость к антибиотикам!
Покраснение, гнойнички, сыпь? Узнайте все о бактериальных инфекциях кожи: причины появления, основные симптомы и эффективные методы лечения. Не игнорируйте проблему!
Заметили странные пятна на листьях? Узнайте, как распознать и вылечить бактериоз комнатных растений! Советы по профилактике и спасению любимых цветов.
Узнайте все о бактериальных инфекциях! Причины, симптомы, современные методы лечения и эффективные способы профилактики. Защитите свое здоровье!